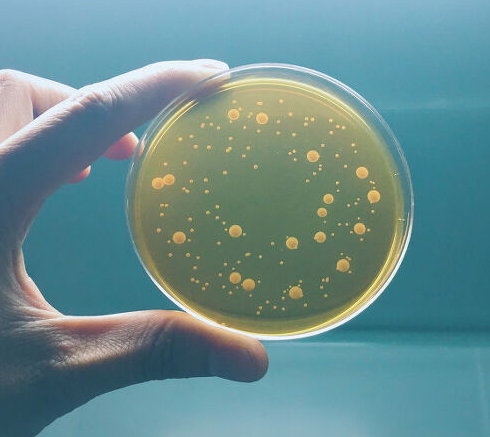

우리 몸에 가장 중요한 부위가 어디라고 생각하시나요.
전 요즘 장 건강에 대한 고민을 무척 많이 합니다.
면역력을 무조건 높이는 게 중요한 요즘 관심을 갖게 된 유산균,
하지만 어떤 식으로 먹는게 가장 효과적인지 가끔 궁금해했습니다.
아침마다 복용중인 유산균을 잘 섭취하고 있는 건지 알아보도록 하겠습니다.

면역관리에 필수적이라고 생각되는 유산균은 어떤 효능이 있을까요.
우리나라에는 유산균이 많이 들어있는 음식으로 김치 그리고 청국장을 예로 많이 듭니다.
유산균은 장 건강에 도움을
많이 주기에 많은 분들이 챙겨드시고 있으리라 생각됩니다.

면역력에는 선천적, 후천적 면역력이 있다고 합니다.
선천면역은 태어날때부터 가진 면역력이고
후천면역은 감염, 예방접종, 면역력 영양제 등을 통해
얻은 면역력이라고 생각하면 됩니다.
그렇기에 후천 면역력은 얼마든지 각자의 노력에 의해 좋아질 수도 나빠질 수도 있는 거 같습니다.
유산균은 위산과 만나면 사멸되기에 장까지 도착하기 힘든 확률이 높습니다.
그래서 최대한 도착할 수 있도록 캡슐, 분말, 음료 등 다양하게 나오는 유산균 중
캡슐 형태가 위산에서 더 잘 버텨낸다고 합니다.
유산균은 일반적으로 건강한 사람들에게는 부작용을 일으키지않기에
좀 더 효과를 보기 위해서는
나에게 맞는 제품을 꾸준히 섭취하는 것만 잘 지켜주시면 됩니다.
-장 건강에 도움
-혈액순환에 도움
-피부질환 개선
-감기 예방

우리 몸에 많이 좋다고 하더라도
유산균을 너무 많이 섭취하게 되면 복부 팽만감이나 설사, 변비 등의 증상이 나타날 수 있습니다.
또 유제품 알레르기가 있으신 분들은 조심하시기 바랍니다.

유산 먹는 시간이 따로 있나? 챙겨 먹으면 좋은 거 아닌가 싶다가도
더 좋은 효과를 보려면 어찌하는게 좋을까 생각할 때도 있습니다.
저뿐 아니라 가족들도 챙겨야하니까요.
유산균을 최대한 살려 장까지 도달하게 해야 하기에 유산균 먹는 시간이 중요하다고 합니다.
유산균은 식전이나 혹은 공복에 먹는게 좋은데 이건 위의 산성이 낮은 상태이기 때문입니다.
음식물을 섭취하면 담즙이 나와 그만큼 유산균이 줄어들기 때문에 장까지 도착하기 힘들어집니다.

각자 생활패턴이 다 다르기 때문에 아침 식사를 챙겨 먹지 못하는 분들이 계시잖아요.
보통 유산균먹는 시간은 아침 공복에 먹는 걸 권장합니다.
또한 아침식사를 대비해 위산 분비를 줄이기 위해 공복인 상태에서 찬물로 함께 마시는 것이 좋다고 합니다.
한 가지 팁. 유산균을 먹으면서 유산균의 먹이인 '프로바이오틱스'를 같이 먹을 때 시너지 효과를 볼 수 있다고 합니다.

시간도 중요하지만 뭐든 꾸준히 매일매일
챙겨 먹는게 무엇보다도 중요한 거 같습니다.
먹는 시간보다도 매일 같은 시간 꾸준히 빼놓지 않고
드시기는 걸 추천합니다.
건강합시다!